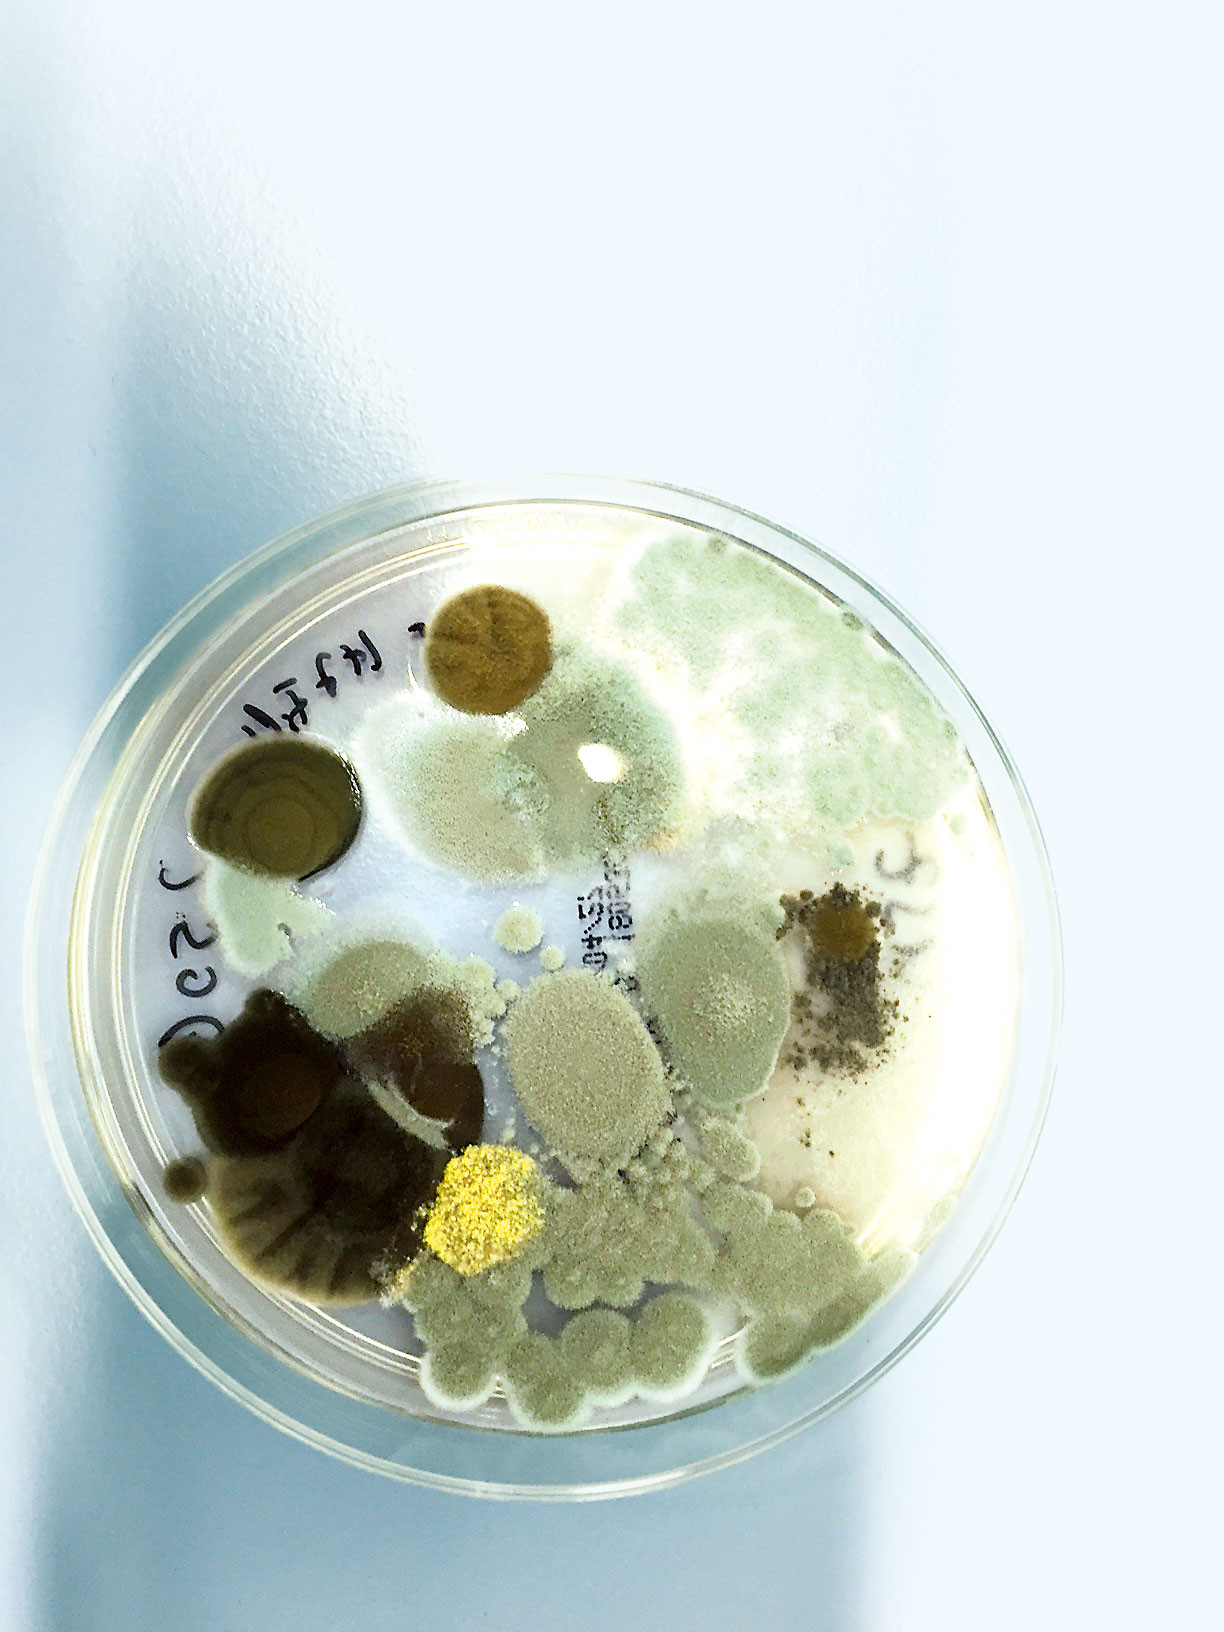
Schimmelpilzbehandlung.jpg (1)

Wasserschäden in Gebäuden erfordern nicht nur ein rasches, sondern vor allem ein kompetentes Vorgehen zur Verhinderung von Folgeschäden. Darüber hinaus ist es besonders wichtig, mikrobiologische Kontaminationen, die durch Schimmelpilzsporen entstehen können, zu verhindern oder nachhaltig zu beseitigen.



Sanierung von Wasserschäden
Unsere Experten unterstützen Sie mit mikrobiologischen Kenntnissen in der Schimmelpilzsanierung und Dekontamination.
Situationsanalyse
Nach einem Wasserschaden gilt es zuerst, das Wasser abzusaugen und abzupumpen. Anschliessend erfolgt die schnelle und kompetente Begutachtung des Schadens durch Fachpersonal. Das Festlegen der richtigen Austrocknungs- und Sanierungsmassnahmen inklusive eines geeigneten Zonenkonzeptes verhindert eine Kontamination, die durch Schimmelpilzsporen entstehen kann. Wir stehen Ihnen von Beginn an mit Experten, die mikrobiologische Kenntnisse und Erfahrungen in der Schimmelpilzsanierung und Dekontamination haben, zur Verfügung. Ein Alleingang ohne die notwendige Kompetenz kann zur Folge haben, dass sich Schimmelpilzsporen schnell ausbreiten und aus dem Wasserschaden Folgeschäden mit erheblichen Gesundheitsrisiken und hohen Sanierungskosten entstehen.
Koordinierter Ablauf
Nach der Bestandsaufnahme erarbeiten unsere Enzlerh-tec-Spezialisten das Zonenkonzept sowie der Arbeits- und Zeitplan, in dem alle beteiligten Partner und deren Aufgaben erfasst sind. Das Zonenkonzept ist wichtig, um Kreuzkontaminationen während der Trocknungsphase zu verhindern. Erst nach Trocknung der betroffenen Räume und Bauteile und der Entfernung aller sichtbar mit Schimmel befallenen bzw. verschmutzten Materialien folgen die weiteren Sanierungsschritte. Die fachmännische Durchführung dieser Arbeiten wird durch unsere Hygienespezialisten garantiert und ist essenziell für die erfolgreiche und sichere Sanierung. Bevor die Instandsetzung der mit Schimmel belasteten Bauteile erfolgen kann, wird eine Biodekontamination durchgeführt. Alle sichtbaren und verdeckten Oberflächen sowie die Raumluft werden durch die Begasung mit Wasserstoffperoxid effektiv, rückstandsfrei und umweltschonend von gesundheitsgefährdenden Pilzsporen und mikrobiologischen Kontaminationen befreit. Wenn nötig werden einzelne Flächen zusätzlich manuell desinfiziert. Nach den Dekontaminationsmassnahmen werden die betroffenen Räume instand gesetzt und die Sanierungsarbeiten durch uns abgeschlossen.
Unsere Dienstleistungen
- Schadensbeurteilung
- Schimmelpilzbehandlung
- Desinfektion
- Dekontamination
- Geruchsneutralisation
Ihr Nutzen auf einen Blick
- Projektleitung und Koordination aller erforderlichen Planungen, Arbeiten und Dienstleister
- Qualitätsarbeit und Kosteneffizienz durch ausgewiesene Fachkompetenz
- mikrobiologische Sicherheit durch 6log-Reduktion von Schimmelpilzsporen